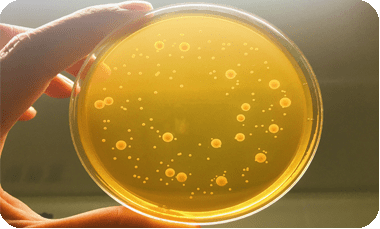

-
1000+ 工艺应用解决方案
-
8000+ 针对行业专用消泡剂
-
2000m² 自主消泡剂研发基地
-
24小时 出定制消泡解决方案
|
1. 微生物发酵工艺 发酵是指人们借助微生物在有氧或无氧条件下的生命活动来制备微生物菌体本身、或者直接代谢产物或次级代谢产物的过程。通常所说的发酵,多是指生物体对于有机物的某种分解过程。如今发酵在食品工业、生物和化学工业中均有广泛应用。 (1)发酵工艺类型 ①按发酵原料来区分:糖类物质发酵、石油发酵及废水发酵等 ②按发酵产物来区分:氨基酸发酵、有机酸发酵、抗生素发酵、酒精发酵、维生素发酵等 ③按发酵形式来区分:固态发酵和液体深层发酵 ④按发酵工艺流程区分:分批发酵、连续发酵和流加发酵 ⑤按发酵过程中对氧的不同需求区分:厌氧发酵、通风发酵 (2)发酵工艺流程 主要包括菌种以及确定的种子培养基和发酵培养基的组成;培养基、发酵罐和辅助设备的活菌;大规模的有活性、纯种的种子培养物的生产;发酵罐中微生物最优的生长条件下产物的大规模生产;产物的提取、纯化;发酵废液的处理等。 2. 微生物发酵原理 (1)通气搅拌的强烈程度:通气大、搅拌强烈可使泡沫增多,因此在发酵前期由于培养基营养成分消耗少,培养基成分丰富,易起泡。应先开小通气量,再逐步加大,搅拌转速也如此。 (2)培养基配比与原料组成:培养基营养丰富,黏度大,产生泡沫多而持久,前期难开搅拌。 (3)菌种、种子质量和接种量:菌种质量好,生长速度快,可溶性氮源较快被利用,泡沫产生几率也就少。菌种生长慢的可以加大接种量。 (4)灭菌质量:培养基灭菌质量不好,糖氮被破坏,抑制微生物生长,使种子菌丝自溶,产生大量泡沫,加消泡剂也无效。 (5)医药发酵行业起泡综合原因:很多情况下都是好氧发酵,通气是重要环节,结合发酵培养基本身就含有许多表面活性物质,如表面活性蛋白类、油类、脂肪酸、酯类、醇类、亚硫酸盐和磺酸盐等,以及发酵过程中菌种又会产生一些表活物,医药发酵过程中产生的泡沫就会相当多。 |
 |
 通气搅拌 |
培养基配比 |
 菌种生长 |
1. 泡沫会使发酵罐的装料系数减少影响相关数值。
2. 泡沫会使氧传递系统减小影响发酵程度。
3. 泡沫过多时,造成大量溢出,发酵液从排气管路或轴封逃出而增加染菌机会。
4. 泡沫严重时通气搅拌也无法进行,菌体呼吸受到阻碍,导致代谢异常或菌体自溶。
5. 消泡剂高温灭菌后达不到消泡效果。
6. 影响生物菌生长。
7. 消泡剂加入后担心会影响产品质量下降导致检测不合格。
8. 消泡剂加入会和产品发生反应破坏本身性质。
9. 消泡剂加入担心会影响微生物的生长。
10. 消泡剂加入会影响脱氢反应、氧化反应、脱水反应、缩合反应、脱羧反应、氨化反应、脱氨反应。
11. 消泡剂加入后担心会有化学反映产生气味。
12. 不能高温灭菌。
13. 不能在发酵期内长时间抑泡。
14. 是否环保。
1. 对消泡剂的要求
(1)在起泡液中不溶或难溶:为破灭泡沫,消泡剂应该在泡膜上浓缩集中,对抑泡的情况也应经常保持在这种状态。用于发酵体系的消泡剂,活性成分的分子应该为强疏水弱亲水,HLB值在1.53范围,作用才更好。
(2)表面张力低于起泡液:只有消泡剂分子间作用力小,表面张力低于起泡液,消泡剂微粒才能够在泡膜上浸入及扩展。
(3)与起泡液有一定程度的亲和性:由于消泡过程实际上是泡沫崩溃速度与泡沫生成速度的竞争,所以发酵用的消泡剂需能快速分散,以便在起泡液中发挥作用。要使消泡剂扩散较快,消泡剂活性成分需与起泡液具有一定程度的亲和性。
(4)与起泡液不发生化学反应:发酵用的消泡剂与起泡液发生反应,一方面消泡剂会丧失作用,另一方面可能产生有害物质,影响微生物的生长。此外,发酵用的消泡剂的挥发性要小,作用时间长。
2. 常用消泡剂的种类和性能
(1)天然油脂:来源容易,价格低且使用简单,一般来说没有明显副作用。主要成分是高级脂肪酸酯和高级一元醇酯,还有高级醇、高级烃等。但油脂如保藏不好,易变质,使酸值增高,对发酵有毒性。
(2)聚醚类: 主要是甘油三羟基聚醚,用于链霉素发酵代替天然油效果更好。此外,由于GP型的抑泡能力比消泡能力强,但亲水性差和溶解度小,宜用在稀薄的发酵液与基础培养基中; GPE型的亲水性较好、易铺展、消泡能力强,但溶解度大、维持时间短,宜用在粘稠发酵液中;还有一种GPES型聚醚消泡剂,分子易于平卧状聚集在气液界面,因而表面活性强,消泡效率高。
(3)高碳醇类:是强疏水弱亲水的线型分子,在水体系里能发挥很好效果。还有些成酯,如苯乙醇油酸酯、苯乙酸月桂醇酯等在青霉素发酵中具有消泡作用。
(4)硅酮类:常用的是聚二甲基硅氧烷(二甲基硅油)。其表面张力低,在水及一般油中的溶解度低且活性高。挥发性低,并具有化学惰性,性能稳定且毒性小,广泛用于抗生素发酵及食品工业。
1.生物发酵消泡剂X-1645/1622/1680:微生物发酵、工业制糖、 食品加工、消除其它的水相泡沫、发酵工业、植物油的脂化加工过程、酵母工业等
特性:消泡快抑泡久,用量少;耐高温,耐强酸强碱;表面张力小,良好的扩散性和渗透性;稳定的化学性能,适应性强,能提高菌种的生长环境,同时不伤害菌种,影响微生物的生长。

2.发酵消泡剂/大肠杆菌发酵消泡剂X-1667/1668:各类发酵生产过程的消泡,如红霉素、洁霉素、阿维菌素、庆大霉素、青霉素、柠檬酸、赖氨酸、酵母生产、生物医药等发酵工艺、菌种培育、制糖、酶制剂、味精、涂料、大豆蛋、卡那霉素、各种氨基酸以及维生素C发酵,在兽药加工、后期提取工艺中也适用
特性:是采用特殊工艺精制而成的、具有生物惰性的专用发酵消泡;符合食品级标准,根据发酵工艺的特点,可直接与基础料一起加入发酵液中,经高温灭菌后流加或补料,克服了发酵前高温消毒的稳定性和发酵过程中对细菌生长的抑制性、及发酵罐结垢缺点, 且发酵后易分离,罐易清洗等;一次加入,可快速消泡、持久抑泡、用量少、得罐率高,耐酸碱性好,化学稳定性优。
3.食品/医用/制糖/果汁/食用菌发酵消泡剂X-1675/1666/1610/1710/1619:青霉素、洁霉素、泰乐菌素、阿维菌素、维生素、VC、柠檬酸、谷氨酸、赖氨酸、大豆蛋白、工业制糖、果汁、食用菌、分歧干菌、黄原胶、血球蛋白、酶制剂、淀粉、酵母、啤酒发酵等
特性:具有耐温性强,使用范围广泛,在130℃高温中杀菌后不破乳、消泡快、抑泡时间长等特点;由于降低了聚醚消泡剂用量,改善了菌种生长环境,可以明显提高效果。
4.氨基酸/肥料/酒精/真菌发酵消泡剂X-1700/1410/1682/1669:食品工艺发酵、酿酒发酵、酒石酸发酵、酒精发酵、酶制剂、味精、大豆蛋、柠檬酸、庆大霉素、卡那霉素、纤维素以及葡萄酒发酵等
特性:具有快速消除泡沫、长久抑止泡沫的特点,能够迅速渗透进泡沫内部到达消泡抑泡效果;适用范围广泛,耐高温、耐酸碱,在各种环境下也能稳定的发挥消泡抑泡的效果,不漂油、不分层、不析出。




版权所有 © 2021-2041鸿泰保留一切权利 © 2021-2028